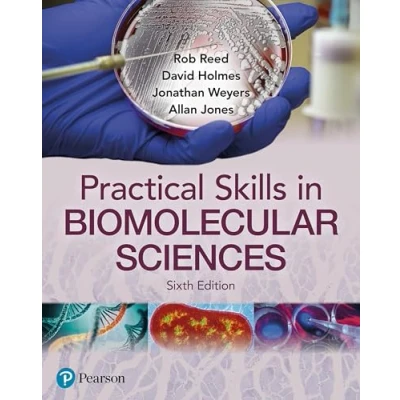

Practical Skills in Biomolecular Science
Prices from
COMPARE ALL WEBSHOPS
(2)
Amazon
Pages: 656, Edition: 6, Paperback, Pearson
Read more
45.42
Featured

|
£ 45.42 |
To Shop
|

|
£ 45.42 |
To Shop
|
 Description
Description
Amazon
Pages: 656, Edition: 6, Paperback, Pearson
Pages: 656, Edition: 6, Paperback, Pearson

Product specifications
Product specifications Related
Related 



